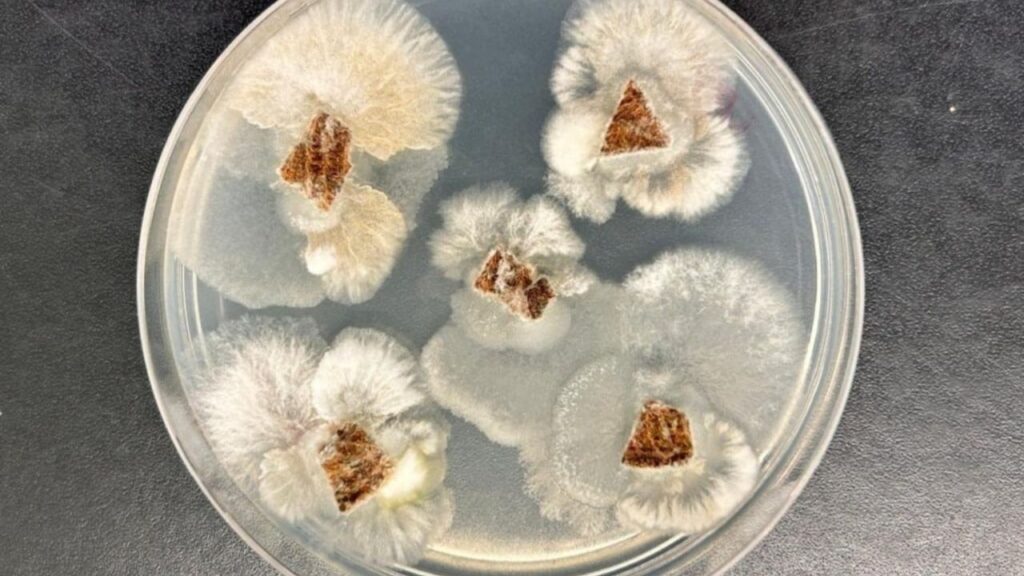
Molécula de fungo nativo supera glifosato em testes de laboratório

Resumo
• Pesquisadores identificaram, em um fungo nativo da Mata Atlântica, uma molécula inédita com desempenho superior ao de herbicidas sintéticos como o glifosato.
• O composto, produzido por um fungo endofítico do gênero Fusarium, mostrou alta eficiência em baixas doses, inibindo a germinação e o crescimento de plantas daninhas.
• A molécula também apresentou ação antifúngica relevante, superando substâncias naturais usadas como referência no controle de patógenos agrícolas.
• A descoberta reforça o potencial da biodiversidade brasileira para gerar bioinsumos mais seguros e sustentáveis, alinhados às demandas da agricultura moderna.
• Para chegar ao campo, o composto ainda passará por testes ambientais, análises de toxicidade e avaliações em lavouras, abrindo caminho para defensivos biológicos de nova geração.
A busca por alternativas mais seguras e sustentáveis aos defensivos químicos ganhou um reforço importante vindo da própria natureza. Pesquisadores brasileiros, em parceria com cientistas dos Estados Unidos, identificaram uma molécula inédita produzida por um fungo nativo que se mostrou mais eficiente do que herbicidas amplamente utilizados, como o glifosato. O resultado, obtido a partir de um organismo microscópico encontrado em uma planta tropical, abre espaço para uma nova geração de bioinsumos agrícolas de alta performance, alinhados à preservação ambiental e à produtividade no campo.
Além de surpreender pelo desempenho, a descoberta reforça o papel estratégico da biodiversidade brasileira como fonte de soluções inovadoras para os desafios da agricultura moderna, especialmente em um cenário de resistência crescente de plantas daninhas e doenças a produtos químicos tradicionais.
Um aliado invisível nas plantas tropicais
O ponto de partida da pesquisa foi um fungo endofítico isolado de uma planta medicinal do gênero Piper, típica de regiões tropicais. Esses microrganismos vivem dentro dos tecidos vegetais sem causar danos, mas, ao contrário, muitas vezes atuam como verdadeiros aliados, ajudando a fortalecer a planta contra pragas, doenças e condições de estresse.
Nesse caso, o fungo pertence ao gênero Fusarium e foi coletado no Parque Estadual da Floresta do Rio Doce, em Minas Gerais, uma área de Mata Atlântica que ainda guarda remanescentes importantes de vegetação nativa. A partir do material coletado, equipes da Universidade Federal de Minas Gerais (UFMG), da Embrapa Meio Ambiente e do Departamento de Agricultura dos Estados Unidos (USDA) passaram a investigar que substâncias esse microrganismo era capaz de produzir.
Durante a análise, os pesquisadores identificaram três metabólitos secundários – compostos químicos gerados no metabolismo do fungo – com atividade herbicida e antifúngica. Entre eles, surgiu uma molécula completamente nova para a ciência, até então não descrita em nenhuma publicação especializada. Foi esse composto, batizado por enquanto como “composto 2”, que chamou mais atenção pelos resultados consistentes nos testes de laboratório.
Molécula natural supera herbicidas consagrados
Quando o desempenho do novo metabólito foi comparado ao de herbicidas sintéticos consolidados no mercado, como o glifosato e a clomazona, os resultados foram surpreendentes. Em concentrações relativamente baixas, a molécula foi capaz de inibir de forma significativa a germinação de sementes e o desenvolvimento de plantas daninhas utilizadas nos bioensaios.
Os testes foram realizados com sementes de alface e de grama-de-bent (Agrostis stolonifera), espécies amplamente empregadas em pesquisas justamente por responderem de forma sensível a substâncias herbicidas. Nas duas plantas, o “composto 2” impediu o avanço do crescimento, provocando efeitos comparáveis – e, em diversos casos, superiores – aos produtos químicos usados como referência.
Além disso, o comportamento da molécula revelou um aspecto importante para o desenvolvimento de futuros defensivos biológicos: a alta eficiência em doses pequenas. Isso significa que, em teoria, seria possível obter controle desejado com menor quantidade de insumo, reduzindo o volume de substâncias aplicadas no ambiente, o que é um ponto central quando se pensa em sustentabilidade e manejo responsável.
Ação antifúngica e potencial para fungicidas biológicos
O desempenho da molécula não se limitou ao controle de plantas daninhas. Nos ensaios de laboratório, o composto também se mostrou altamente eficaz contra o fungo Colletotrichum fragariae, um patógeno que pode afetar diferentes culturas agrícolas e está associado a doenças importantes em plantas.
Nos testes de inibição de crescimento fúngico, o “composto 2” formou zonas de inibição maiores do que as obtidas com fungicidas naturais já conhecidos, como o carvacrol e o timol, frequentemente citados como referências de substâncias com ação antifúngica. Esse diferencial é relevante porque indica que a mesma molécula pode ter dupla aplicação: atuar como herbicida biológico e, ao mesmo tempo, como base para o desenvolvimento de fungicidas de origem natural.
Assim, o fungo endofítico isolado na Mata Atlântica se revela uma verdadeira fábrica microscópica de compostos de interesse agrícola, com potencial de contribuir para o controle integrado de pragas e doenças em sistemas produtivos que buscam reduzir a dependência de moléculas sintéticas.
Biodiversidade brasileira como motor de inovação
Os resultados reforçam uma mensagem que vem ganhando cada vez mais força: a biodiversidade brasileira não é apenas um patrimônio ecológico, mas também um enorme laboratório vivo, ainda pouco explorado, com capacidade de gerar moléculas inéditas e soluções tecnológicas com aplicação direta no campo.
Ao recorrer aos fungos endofíticos, a pesquisa mostra como organismos aparentemente discretos podem esconder capacidades bioquímicas sofisticadas. Esses microrganismos, ao conviverem intimamente com as plantas, acabam desenvolvendo compostos que ajudam a protegê-las ou a mediar interações com o ambiente. Quando isolados e estudados, esses produtos naturais se tornam candidatos promissores para novos bioinsumos.
Além disso, o estudo destaca a importância de áreas de conservação, como o Parque Estadual da Floresta do Rio Doce, para a descoberta de recursos biológicos com potencial econômico e estratégico. Sem essas áreas preservadas, muitas espécies de plantas, fungos e outros organismos seriam perdidas antes mesmo de terem suas propriedades conhecidas.
Do laboratório ao campo: etapas até virar produto
Embora os resultados iniciais sejam animadores, o caminho entre a descoberta de uma molécula potente em laboratório e sua chegada às lavouras como produto comercial é longo e exige cautela. Os pesquisadores ressaltam que ainda são necessárias várias etapas de avaliação antes de qualquer aplicação em larga escala.
Entre os próximos passos estão estudos detalhados de segurança ambiental, testes de toxicidade para diferentes organismos e análises aprofundadas dos mecanismos de ação da molécula, tanto como herbicida quanto como agente antifúngico. Além disso, será preciso verificar como o composto se comporta em condições reais de campo, sujeitas às variações de clima, solo, manejo e interação com outros organismos presentes no agroecossistema.
Essas fases são importantes para garantir que o futuro bioinsumo seja eficaz, mas também seguro para o ambiente, para os agricultores e para os consumidores, respeitando regulamentações rígidas e critérios de agricultura de baixo carbono e menor impacto ambiental.
Hormese: quando a dose baixa estimula o crescimento
Um ponto curioso observado durante os experimentos foi a ocorrência de hormese, fenômeno em que doses muito baixas de determinada substância, em vez de inibir, acabam estimulando o crescimento das plantas. Em concentrações mínimas, o “composto 2” não apenas deixou de prejudicar o desenvolvimento vegetal, como também favoreceu o crescimento em alguns bioensaios.
Esse efeito chama atenção porque abre possibilidades de uso mais amplo da molécula. Em teoria, dependendo da dose e da forma de aplicação, o mesmo composto poderia ser explorado tanto como defensivo biológico quanto, futuramente, como promotor de crescimento, sempre respeitando limites de segurança e critérios agronômicos bem definidos.
Assim, a substância descoberta não se apresenta apenas como um “substituto verde” para herbicidas e fungicidas, mas como uma ferramenta versátil que pode ser lapidada de acordo com as necessidades do sistema produtivo.
Brasil em posição estratégica na era dos bioinsumos
Ao reunir equipes da UFMG, da Embrapa Meio Ambiente e do USDA em torno de um mesmo objetivo, a pesquisa reforça a importância da cooperação científica para avançar em temas de alta complexidade. Mesmo sem a identificação completa da espécie do fungo, a caracterização genética realizada foi suficiente para assegurar a continuidade dos estudos com segurança e rigor.
Os resultados obtidos até agora colocam o Brasil em posição privilegiada na corrida global por bioinsumos de nova geração. Em um cenário em que a agricultura precisa ser, ao mesmo tempo, produtiva e ambientalmente responsável, moléculas naturais capazes de rivalizar e até superar produtos sintéticos representam um diferencial competitivo importante.
Por isso, o “composto 2” não é apenas uma curiosidade científica. Ele simboliza o início de uma linha promissora de pesquisa que pode, no futuro, contribuir para herbicidas e fungicidas mais eficientes, alinhados ao uso inteligente da biodiversidade e a uma agricultura que concilia tecnologia, produtividade e respeito ao ambiente.